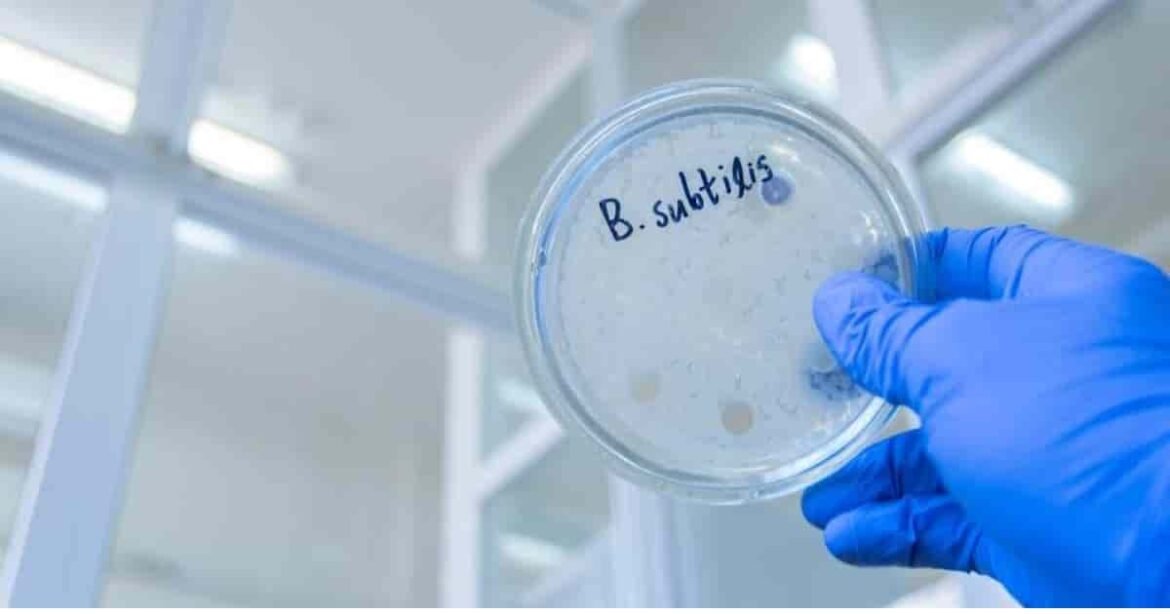

Is it possible to combat fungal infection in plants without chemicals? There are a few possibilities in this pursuit, and one of the best and most natural is Bacillus subtilis (aka hay or grass bacillus.)
This is a natural, soil-dwelling bacteria, and its spore can be found in soils in various environments worldwide.

By harnessing the power of B. subtilis, gardeners and farmers can easily control fungal, bacterial, and microbial threats and bring a wealth of benefits to their plants.
In this article, we’ll explain how B. subtilis fungicide can benefit your garden. Read on to learn more.
Bacillus Subtilis
Bacillus Subtilis Fungicides in the Past
B. subtilis is a Gram-positive bacterium that has played a significant role in the history of fungicides.
The use of B. subtilis as a fungicide dates back several decades. Its first recorded use can be traced back to the 1940s.
In the early years, B. subtilis was mostly used in agricultural and horticultural practices to combat fungal diseases that affected crops and plants.
Farmers and gardeners recognized its potential as a natural and effective alternative to synthetic chemical fungicides.
Over time, research and advancements in biotechnology have further enhanced our understanding of B. subtilis and its antifungal properties, so today, we have many refined formulations and application methods from which to choose.
How Does B. Subtilis Prevent or Kill Pathogens & Fungal Growth?
The various strains of B. subtilis produce over two dozen different types of antibiotics to protect plants. These antibiotics are of a special sort known as lipopeptides. In Latin, lipo means lipid or fat.
Peptide refers to amino acids that are linked together by peptide bonds. These short amino acid chains are protein-building blocks.
Lipopeptides often have antiviral, antimicrobial, and immunomodulatory abilities and are also effective in breaking down fungal growth.
These special antibiotics break down the membranes of fungal cells (which consist of lipids). This results in the death of the fungi, as explained in this video.
Serenade Fungicide Mode of Action
How B. Subtilis Works to Protect Plants from Fungal Diseases
This beneficial bacterium produces many different antibiotic compounds (lipopeptides.) It can also form endospores and biofilms on the roots’ surfaces. This helps block fungal growth.
Interestingly, these activities are more powerful in wild strains of B. subtilis than in commercial or laboratory strains.
Simultaneously, the natural boost in the plants’ resistance helps it combat microbial infection, and this added strength also helps the plant resist fungal infestation.
How Does B. Subtilis Colonize on Plant Roots?
Plant roots secrete various compounds and sugars that feed B. subtilis’ beneficial microbes.
The area around plant roots is very alluring to these little microscopic helpers, and so they naturally congregate and colonize there. This creates a symbiotic relationship in which all participants are nourished and protected.
This safe space around a plant’s roots is known as the rhizosphere, and the B. subtilis species that colonize plant roots belong to a bacteria group known as Plant Growth Promoting Rhizobacteria (PGPR).
PGPR works to form a protective biofilm on the roots of plants. The biofilm is made up of bacteria embedded within a matrix made up of chemicals produced by the bacterial cells. As such, they are perfectly positioned to keep threatening plant pathogens at bay.
How B. Subtilis Helps Nourish Your Plants
This all-natural, eco-friendly fungicide and biopesticide not only helps farmers and gardeners battle fungal infections and some microbial pests, but it also helps stimulate growth in plants by producing and releasing natural substances such as:
- Auxins: Plant hormones that help regulate plant growth and development. They assist with cell elongation and root formation and enhance photosynthesis. They also promote successful stem and leaf growth and fruit development.
- Cytokinins: Plant hormones that support cell division, differentiation, and proliferation. Healthy cytokinins are vital in producing root tips and other new growth. Cytokinins work together with auxins to achieve balanced plant growth and development.
- Gibberellins: Plant hormones that affect various growth processes, such as cell division, stem elongation, and differentiation. They regulate plant growth and development aspects, such as seed germination and flowering, fruit development, and the awakening of dormant seeds.
B. subtilis can also work in concert with other beneficial flora, such as mycorrhizae. This type of beneficial fungus lives on the roots of plants and assists in nutrient absorption.
B. subtilis and one specific type of beneficial fungus, arbuscular mycorrhizae (AM), work together synergistically to help plants absorb nutrients such as phosphorus.
Seven Benefits of Using B. Subtilis as a Fungicide
Using B. subtilis is beneficial to your yard, garden, and crops in multiple ways.
B. subtilis fungicide can be used to protect plants against many phytopathogenic attacks by working as a microbial pesticide in battling plant diseases and as a biofertilizer to enhance plant health, growth, and yield.
1. Nutrition
The bacterium nourishes growing plants to help them attain robust levels of growth and health and strong immune function.
It does this by converting difficult-to-absorb materials in the soil into substances that are easy for your plants to absorb and utilize.
2. Systemic Acquired Resistance or SAR
Besides strengthening your plants’ immune system by delivering good nourishment, this bacterium also secretes active substances that awaken and activate the plants’ defense systems. This greatly increases your plants’ resistance and immunity against various pathogenic bacteria.
3. Antibacterial Properties
This living, all-natural, microscopic garden helper is always hard at work producing antibacterial substances (e.g., subtilin, antibacterial proteins, organic acids) and engaging in bacteriostatic activities.
These substances are very effective at preventing pathogenic bacteria from reproducing and growing. In fact, they can even destroy some negative bacteria and kill some pathogens.
For this reason, B. subtilis is an excellent preventative and treatment for fungal diseases such as gray mold, double rot, and root rot.
4. Soil Structure Improvement
B. subtilis improves soil structure by decomposing residual pesticides in the soil, altering the structure of microbial soil flora, and regulating nutrients in the soil.
When you apply B. subtilis to your soil, it helps increase the amount of:
- Available phosphorus
- Available potassium
- Alkaline nitrogen
- Total potassium
Incorporating these beneficial bacteria into your soil helps increase the amount of organic matter to produce the lighter, more breathable, well-draining soil that all plants love.
5. Crop Quality Improves Naturally
As B. subtilis colonizes your soil, it produces abundant amounts of organic acids and plant hormones that work together to create a balanced ecosystem that supports your plants in growing strong roots and developing robust metabolic systems.
6. Speed Up Straw Composting
Straw and other natural, organic materials decompose much more rapidly when you add B. subtilis during composting.
7. Long-lasting
B. subtilis is a long-lasting solution to keeping your yard, garden, and crops free of pathogens and fungus. Because this rugged beneficial bacteria naturally colonizes your soil and can survive very harsh conditions (e.g., drought, heat, severe cold), you will not need to reapply it frequently.
When conditions are inhospitable (for bacteria and plants) B. subtilis may become dormant, but when the environment becomes habitable again, the spores will begin germinating again.
When the spores have germinated and grown into a full-blown beneficial bacterium, they are equipped with sensors that guide them to plants to get busy colonizing and producing hormones, antibiotics, and physical barriers against fungal and bacterial invaders.
B. subtilis bacteria can survive in the soil for extremely long periods. Thus established, some very effective strains colonize the roots of plants to keep plant pathogens under control.
Additionally, the bacterium works directly against other types of microbes by manufacturing various effective antibiotics against other bacteria and fungi.
Simultaneously, B. subtilis stimulates plants to develop robust natural defense mechanisms so that they can fight off microbial attacks.
Product Selection & Application Methods for B. Subtilis Fungicide
Because B. subtilis delivers two-punch protection, it is widely recognized as a powerful form of biocontrol that inhibits multiple types of pathogens on many crops.
For this reason, a wide variety of products containing this powerful, natural antifungal are easy to find in yard, garden, and farm supply stores.
It’s always wise to seek out an established brand. You may find B. subtilis as a component of a wide variety of organic products, such as:
1. Biofungicides formulated to control fungal diseases such as damping off, gray mold, and powdery mildew.
2. Biopesticides formulated to control insect pests, such as mites, beetles, and caterpillars.
3. Soil probiotic amendments that are formulated to improve soil health, enhancing the availability of nutrients and promoting plant growth.
4. Seed treatments often contain B. subtilis to help promote germination and protect the seeds against soil-borne pathogens.
5. Plant growth promoters are designed to improve nutrient uptake, stimulate root development and enhance plant vigor. These may be available as soil drenches or foliar products.
It is difficult to recommend specific products as availability and effectiveness may vary from place to place.
There are so many strains of this beneficial bacteria it can be hard to know exactly what you need. Each strain behaves differently and may produce very different results.
To be sure of getting a strain (or combination of strains) that will be effective in your setting, check with your local agricultural extension and talk with local gardeners and farmers to determine the best products for use in your area.
Amazing Results Fighting Garden Disease with Healthy Bacteria
Serenade was a very popular brand of B. subtilis fungicide containing the QST 713 strain, but it is currently out of production. Seek out other products that list B. subtilis as an ingredient on the label.
CEASE is another very popular version of this product. The concentrate is only available in large-size bottles. Be sure to follow packaging directions closely.
CEASE Biological Fungicide Review and How to Use
Incorporating this beneficial bacterium into your everyday natural gardening practices is generally a good idea.
Apply it as a soil drench or amendment, or foliar treatment immediately if you see signs of disease among your plants.
Generally speaking, once or twice weekly use is recommended as a fungal or bacterial treatment, but be sure to follow the packaging directions for the product you choose.
Compatibility of B. Subtilis With Other Pesticides and Fertilizers
B. subtilis is an excellent, ongoing addition to any organic gardening plan or Integrated Pest Management (IPM) plan.
It can be used with any sort of natural pest management technique or product; however, because it is a living organism, large amounts of harsh chemicals, herbicides, pesticides, and poisons are likely to impact it negatively.
It should never be mixed with acid-containing products or with any sort of copper-based fungicide.
Safety Considerations When Using B. Subtilis Fungicide
B. subtilis is generally considered safe and can be used in any growing setting on any type of plant.
It’s safe for use in organic food production, and it is effective against a wide variety of fungal infections, such as:
- Didymella bryoniae
- Powdery Mildew
- Anthracnose
- Sclerotinia
- Botrytis
It’s also effective against several leaf spot diseases, including:
- Entomosporium
- Alternaria
B. subtilis also controls several bacterial diseases, such as:
- Xanthomonas spp
- Pseudomonas
- Erwinia
And the soil diseases:
- Phytophthora
- Rhizoctonia
- Fusarium
- Pythium
This all-natural bacterium is safe for food crops and does not leave any toxic residue on plant leaves or flowers.
It poses no danger to beneficial insects and pollinators, such as bees, butterflies, and hummingbirds.
Although B. subtilis is essentially non-toxic, prolonged exposure to it could be irritating. You should take normal precautions when applying this (or any) substance to your plants.
Wear gloves, eye protection, long sleeves, and pants. Avoid breathing the mist or dust arising from the application of the product. Wear a filtering respirator if you apply a large amount of B. subtilis.
Always read product labels carefully and follow instructions precisely. Remember that the label is the law when using any sort of fungicide or pesticide.
There Is No Downside To Using B. Subtilis In Your Yard & Garden
B. subtilis is a beneficial soil organism that can control both foliar and root pathogens by colonizing plant roots and directly engaging soil-borne pathogens while simultaneously providing systemic support to help plants naturally resist foliar pathogens.
Because B. subtilis can form spores, it provides long-lasting plant support in the soil.
Once the bacterium is established and colonized, you can expect them to continue reproducing and spreading throughout your healthy soil as long as you continue sound IPM or organic gardening practices.
The healthy conditions produced by a strong population of B. subtilis in the soil help plants of all sorts attain vibrant, robust growth.